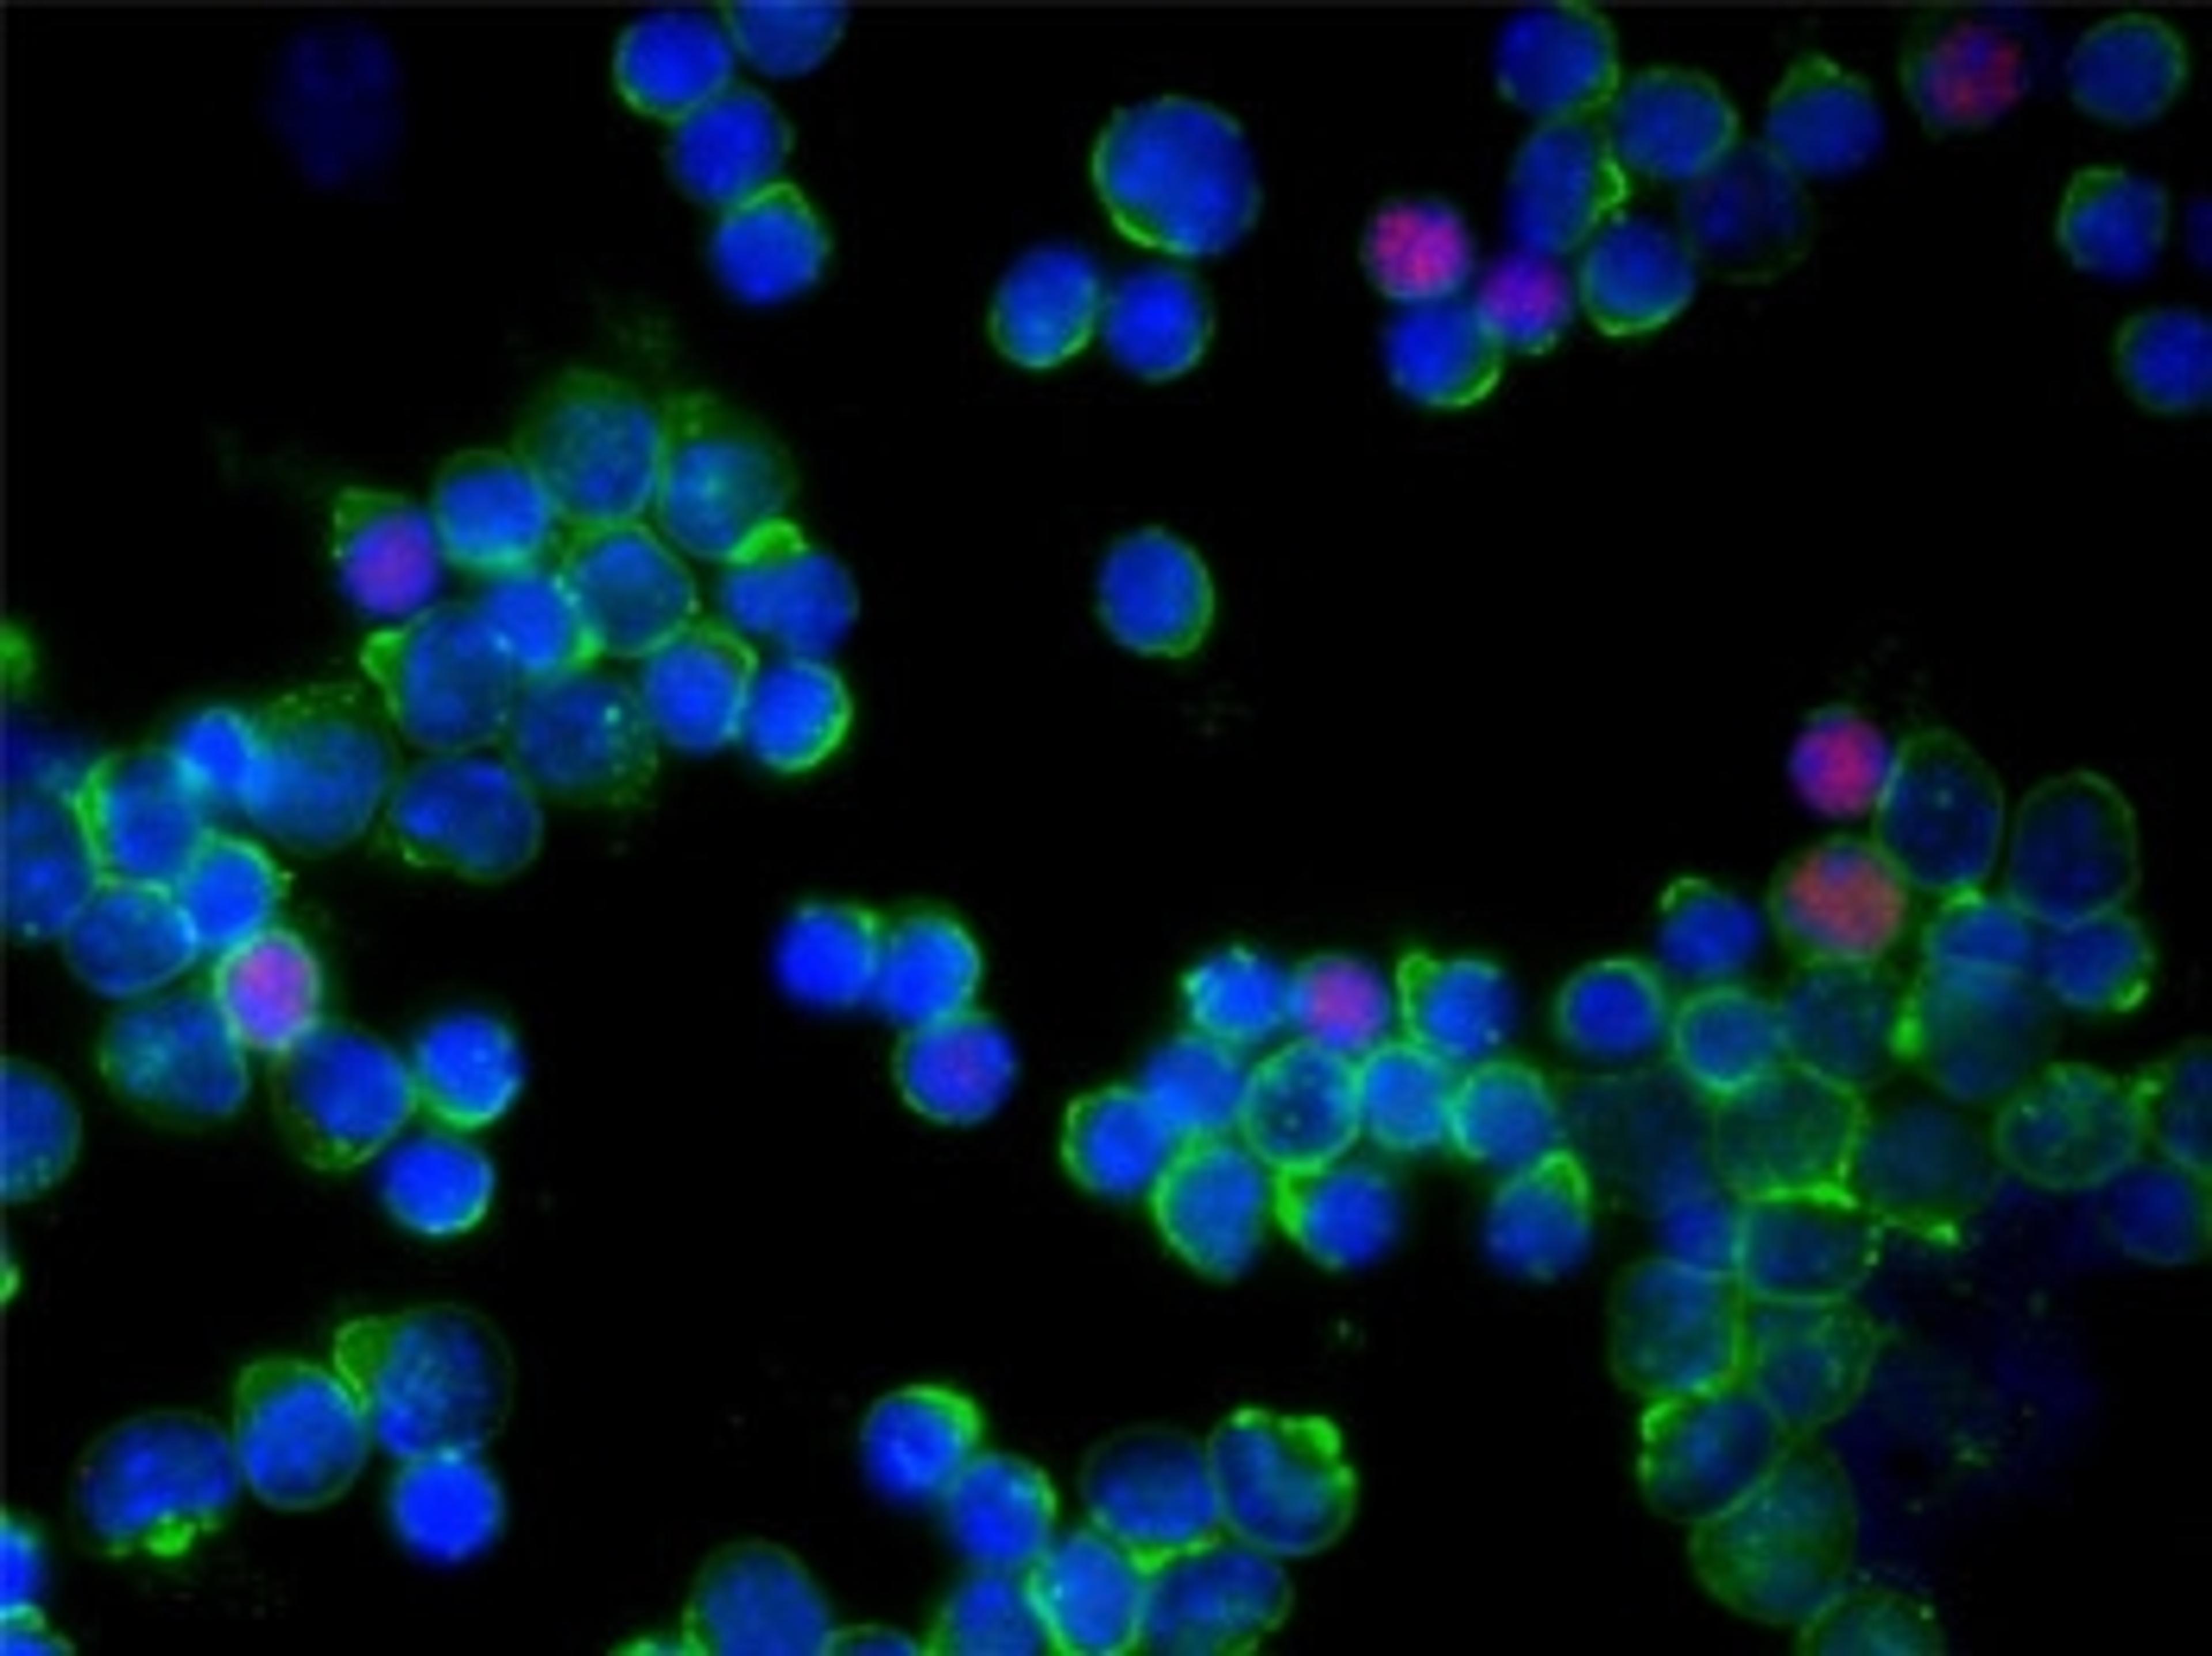

Ambient ionization mass spectrometry in space and time: From high throughput analysis to molecular imaging
Join us Thursday, October 22, to explore the applications and benefits of ambient ionization for biomedical research and its future potential for pharma and food industries